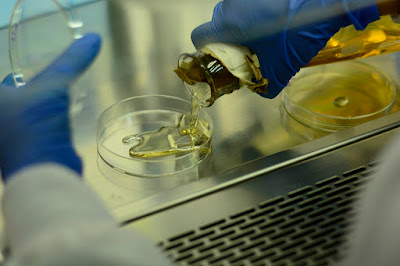

Morado, pequeño y delicioso, el arándano se ha convertido en una joya agrícola para el país. Aunque su cultivo es exigente y requiere suelos ácidos para prosperar, en municipios como Sotaquirá (Boyacá) la fibra de coco se ha vuelto una inesperada fórmula que está revolucionando la forma de sembrarlo, gracias a sus propiedades para mejorar la respiración de las raíces, retener humedad y facilitar el fertirriego.
El fertirriego es una técnica que combina riego y fertilización en un solo paso y se ha convertido en una de las claves para el cultivo eficiente del arándano. Así, los nutrientes se disuelven en el agua y llegan directamente a las raíces a través de tuberías, mangueras y goteros, lo cual permite nutrir cada planta con precisión y sin desperdicios.
El ingeniero agrícola Carlos González Murillo, profesor de la Facultad de Ciencias Agrarias de la Universidad Nacional de Colombia (UNAL) Sede Bogotá, experto en fertirriego sobre sustratos, ha trabajado por más de 10 años en esta área y compartió su experiencia durante una charla ofrecida en la XXV Agroexpo, en donde presentó avances y recomendaciones para aplicar esta técnica en cultivos como flores, y más recientemente en arándanos
Esta técnica funciona especialmente bien cuando se cultiva
sobre sustratos artificiales como la fibra de coco, la cascarilla de arroz o la
corteza de pino. Estos materiales permiten crear camas sobre el suelo, que
protegen las raíces de enfermedades y ofrecen condiciones más controladas. En
el caso del arándano, la fibra de coco es ideal porque tiene un pH ajustable
—perfecto para esta planta, que prefiere suelos entre 4,5 y 5,5—, y además
facilita la aireación y la retención de agua sin generar encharcamientos.
“Este tipo de producción sobre sustrato comenzó a expandirse
en Colombia debido a la necesidad de enfrentar problemas como el hongo Fusarium
oxysporum, que afecta cultivos en suelo tradicional, especialmente en
flores como el clavel y la rosa. Dicho microorganismo ataca las raíces y
bloquea el transporte de agua y nutrientes en la planta causando
marchitamiento; aunque una de las plantas que más ataca es el plátano, aún no
se usan sustratos en sus suelos”, explica el experto.
Comenta además que “empezamos a trabajar en esto cuando una
de las principales empresas floricultoras del país llegó a la Universidad
buscando soluciones, pues a los dos o tres años sus cultivos en suelo estaban
perdiendo productividad”.
“Desde entonces el uso de sustratos ha demostrado ser una
herramienta eficaz; hoy entre un 40 y 50 % de los cultivos de rosa y
clavel se siembran en sustratos como fibra de coco o cascarilla de arroz, y esa
misma tecnología se está empezando a aplicar con éxito en el arándano”,
destaca.
Por ejemplo en Sotaquirá (Boyacá) ya hay unas 120 hectáreas
de arándano sembradas en sustrato, y se espera que en los próximos años esa
cifra llegue a las 300 hectáreas, gracias a los buenos resultados que ha
demostrado esta técnica.
Fórmula para un cultivo más eficiente
El potencial del sustrato de fibra de coco es notable: puede
durar entre 2 y 4 años sin perder sus propiedades físicas, permite
una alta densidad de siembra, mejora la eficiencia del riego y reduce el uso de
fertilizantes.
“Además el país tiene condiciones climáticas y geográficas
ideales para producir esta fibra localmente, en particular en regiones como el
Pacífico colombiano o el departamento del Cesar, lo que evitaría depender de
importaciones desde países como India o Indonesia”, anota el ingeniero
González.
Agregó que otros cultivos estratégicos, como el aguacate
Hass o el cannabis medicinal, también se beneficiarían del uso de sustratos y
fertirriego, aunque aún falta investigación adaptada a cada uno.
“Es fundamental que todos los productores comprendan que si
tienen sustratos homogéneos pueden aplicar cantidades iguales de agua y
nutrientes, lo que hace más eficiente todo el sistema. Ese es el corazón del
fertirriego: la uniformidad y el control”, explica.
Según la agencia gubernamental Procolombia, el arándano es
un cultivo que ha logrado cuadruplicar su producción desde el 2019; además en
2023 Colombia exportó más de 638 kilos de este alimento, generando más 3,3
millones de dólares.
Por eso, tener cada vez más una mejor producción de arándano
es fundamental para los productores, lo cual ya se está implementando en
lugares como Sotaquirá y Tenjo (Cundinamarca), con el conocimiento aportado por
el profesor González y su equipo de trabajo, quienes ofrecen una técnica para
potenciar de manera importante la capacidad de este cultivo para soportar
suelos que no tienen la acidez que necesita, fortalecer las raíces y la
respiración de la planta, y por ende sus frutos.

No hay comentarios:
Publicar un comentario